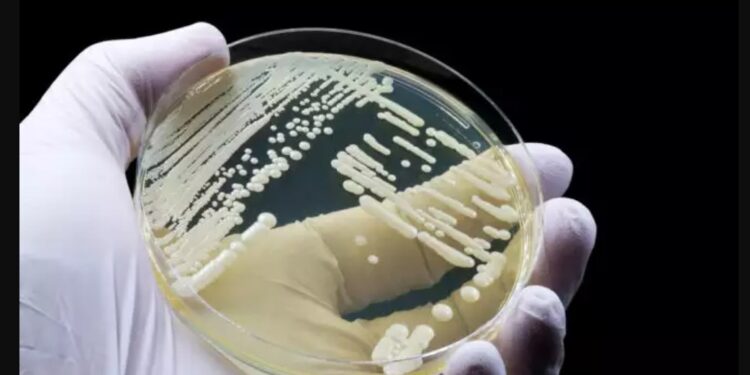
Alldaynews.gr Συναγερμός και στην Ελλάδα για τον μύκητα Candida auris-Γιατί ανησυχεί τόσο πολύ τους ειδικούς

Τι αναφέρει η καθηγήτρια Ελένη Γιαμαρέλλου. Τι προκαλεί στους ασθενείς που μολύνει και πως αντιμετωπίζεται.
Ο μύκητας candida auris είναι ένας καινούργιος παθογόνος μικροοργανισμός που απομονώθηκε για πρώτη φορά μόλις το 2009 στην Ιαπωνία. Από το 2011 και μετά, που εντοπίστηκε για πρώτη φορά στο αίμα ασθενών στη Νότια Κορέα, έως σήμερα, τα κρούσματα στα νοσοκομεία αυξάνονται με γεωμετρική πρόοδο.
Η ομότιμη καθηγήτρια Ελένη Γιαμαρέλλου, παθολόγος-λοιμωξιολόγος, πρόεδρος της Επιτροπής Νοσοκομειακών Λοιμώξεων του Νοσοκομείου ΥΓΕΙΑ, εξηγεί τι πρέπει να γνωρίζουμε γι’ αυτόν.
Πότε ανιχνεύθηκε για πρώτη φορά στη χώρα μας;
Η πρώτη απόμόνωση του μύκητα στη χώρα μας έγινε το 2019. Έκτοτε, απομονώνεται από διεισδυτικές λοιμώξεις (όπως οι καντινταιμίες), σε βαρέως πάσχοντες με μακροχρόνιες νοσηλείες, καθώς και σε ανοσοκατεσταλμένους ασθενείς.
Η Candida auris αποικίζει το δέρμα ασθενών και προσωπικού, καθώς και το άψυχο περιβάλλον, απ’ όπου και μπορεί να μεταδοθεί. Στην πραγματικότητα, οι λοιμώξεις από αυτόν τον μύκητα προκαλούνται κυρίως με τη μεταφορά του με τα χέρια του ιατρονοσηλευτικού προσωπικού ή από το αποικισμένο άψυχο περιβάλλον με τα χέρια του ίδιου του ασθενούς ή του προσωπικού.
Αυτή είναι ουσιώδης διαφορά από έναν άλλο μύκητα, την Candida albicans, για την οποία η πηγή της κλινικής λοίμωξης είναι συνήθως η χλωρίδα του γαστρεντερικού του ιδίου του ασθενούς.
Τι προκαλεί;
Ο μύκητας candida auris προκαλεί σοβαρές μυκηταιμίες, λοιμώξεις μαλακών μορίων και λοιμώξεις χειρουργικού πεδίου. Οι λοιμώξεις του αναπνευστικού είναι σπάνιες.
Κοινός παράγοντας κινδύνου είναι η παρατεταμένη νοσηλεία με επεμβατικούς χειρισμούς, όπως:
- Η διασωλήνωση
- Η τοποθέτηση κεντρικών ενδαγγειακών καθετήρων
Το παθογόνο προσβάλλει συνήθως βαρέως πάσχοντες με μακρά νοσηλεία, οι οποίοι έχουν εισαχθεί στο νοσοκομείο για άλλο λόγο. Οι ασθενείς αυτοί εμφανίζουν αποικισμό ή λοίμωξη κατά τη διάρκεια της μακράς νοσηλείας τους. Ο μύκητας φιλεί ιδιαιτέρως και τους ανοσοκατεσταλμένους ασθενείς.
Η θνητότητα μπορεί να φτάσει έως 70% σε περιστατικά μυκηταιμίας. Κατά κανόνα πρόκειται για ασθενείς ήδη πολύ επιβαρυμένους, με επιπλεγμένα υποκείμενα νοσήματα.
Ποια είναι τα χαρακτηριστικά γνωρίσματα του μύκητα;
Ο ΕΟΔΥ σε πρόσφατη ανακοίνωση ανέφερε για τη χώρα μας ότι ο μύκητας candida auris αποτελεί το 4,4% των ενδονοσοκομειακών μικροβιαιμιών – ποσοστό όχι αμελητέο. Είναι χαρακτηριστικό ότι ο μύκητας εμφανίζει:
- Επιδημίες κατά κανόνα σε Μονάδες Υγειονομικής Περίθαλψης και Μονάδες Εντατικής Θεραπείας. Γι’ αυτό τον λόγο η έγκαιρη ανίχνευσή του είναι σημαντική (αλλά και χρονοβόρα). Είναι απαραίτητο να λαμβάνονται ειδικά μέτρα για την πρόληψη της διασποράς στο νοσοκομειακό περιβάλλον.
- Αντοχή στα αντιμυκητιακά φάρμακα (π.χ. αζόλες) ή και σε άλλες κατηγορίες αντιμυκητικών (π.χ. εχινοκανδίνες, αμφοτερικίνη Β). Τα φάρμακα αυτά χρησιμοποιούνται για τη θεραπεία διεισδυτικών λοιμώξεων από ποικίλα στελέχη Candida.
- Δυσκολίες στην ταυτοποίηση με τις συνήθεις εργαστηριακές μεθόδους. Η εσφαλμένη ταυτοποίηση του (ως Candida parapsilosis) θα οδηγήσει σε λανθασμένη διαχείριση και θεραπευτική αντιμετώπιση των ασθενών. Γι’ αυτό απαιτείται στενή συνεργασία των κλινικών ιατρών με το Μικροβιολογικό Εργαστήριο.
- Δυσκολίες στην εκρίζωσή του τόσο από το δέρμα αποικισμένων ασθενών, όσο και από τις άψυχες επιφάνειες. Ο μύκητας παράγει βιομεμβράνη με την οποία προσκολλάται, ώστε πολλά αντισηπτικά να μην είναι δραστικά.
Πώς αντιμετωπίζεται;
Οι περισσότερες λοιμώξεις από C. auris αντιμετωπίζονται με χορήγηση εχινοκανδινών, εφόσον διαπιστωθεί ευαισθησία στο μυκητόγραμμα. Ωστόσο, αναφέρονται στελέχη C. auris ανθεκτικά σε όλες τις κύριες κατηγορίες αντιμυκητιακών φαρμάκων, ώστε να χορηγούνται εμπειρικοί συνδυασμοί.
Δεν δίδεται αντιμυκητιακή αγωγή σε ασθενείς αποικισμένους με candida auris, χωρίς διηθητική μυκητιασική λοίμωξη.
Στο 22ο Πανελλήνιο Συνέδριο Λοιμώξεων της Ελληνικής Εταιρείας Λοιμώξεων (Μάρτιος 2-5/2023) από μεγάλο ελληνικό τριτοβάθμιο νοσοκομείο ανακοινώθηκαν επίσημα 75 κρούσματα για το 2022 (20 ασθενείς το 1ο και 55 το 2ο εξάμηνο).
Το 64% νοσηλευόταν στη ΜΕΘ και το 36% σε Παθολογικές Κλινικές. Το 28% αφορούσε COVID-19 Κλινικές και το 38,6% είχε πρόσφατα νοσηλεία σε Υγειονομική Δομή. Η C. auris απομονώθηκε κυρίως στο αίμα (30,7%), στο άκρο κεντρικού καθετήρα (14,7%) και στο δέρμα (36%).
Είναι χαρακτηριστικό ότι κατά το 2ο εξάμηνο της μελέτης η απομόνωση C. Auris αυξήθηκε κατά 2,5 φορές. Η φορεία των νοσηλευόμενων αυξήθηκε κατά 42%! Η διασπορά αποδόθηκε στην έλλειψη εφαρμογής των μέτρων απολύμανσης-απομόνωσης.
Παρ’ όλη την επιστημονική διεθνή απαισιοδοξία, από τις ελληνικές Μ.Ε.Θ. στο ίδιο Πανελλήνιο Συνέδριο Λοιμώξεων ανακοινώθηκε ο επιτυχής έλεγχος της απομόνωσης Candida auris σε ΜΕΘ τριτοβάθμιου νοσοκομείου με την αυστηρή τήρηση:
- Των βασικών προφυλάξεων
- Των προφυλάξεων επαφής
- Της σωστής και πιστής εφαρμογής της υγιεινής των χεριών
- Χωροταξικής απομόνωσης των θετικών κρουσμάτων
- Διαχωρισμό νοσηλευτών με ανάθεση της φροντίδας των ασθενών με C. auris σε συγκεκριμένο νοσηλευτή σε κάθε βάρδια
- Χρήση αποκλειστικού ιατρικού εξοπλισμού
- Επιμελή καθαριότητα των αντικειμένων και των επιφανειών σε καθημερινή βάση με τα κατάλληλα αντισηπτικά (χλωροξιδίνη).
Επιπλέον, πραγματοποιήθηκε έλεγχος αποικισμού (δέρμα, μασχάλες και μικροβουβωνικών πτυχών) σε κάθε νοσηλευόμενο ασθενή στη ΜΕΘ δύο φορές την εβδομάδα και έλεγχος του περιβάλλοντας εβδομαδιαίως.
Η εφαρμογή των παραπάνω μέτρων είχε ως αποτέλεσμα όχι μόνο να ελεγχθεί η διασπορά της Candida auris στη ΜΕΘ, αλλά και να αποφευχθεί η διασπορά του μύκητα στο Νοσοκομείο.
Πηγή: iatropedia.gr
To «alldaynews.gr» αποποιείται κάθε ευθύνη από τις αναδημοσιεύσεις άρθρων τρίτων ιστοσελίδων, για τα οποία (άρθρα) την ευθύνη την έχει ο υπογράφων ως πηγή.